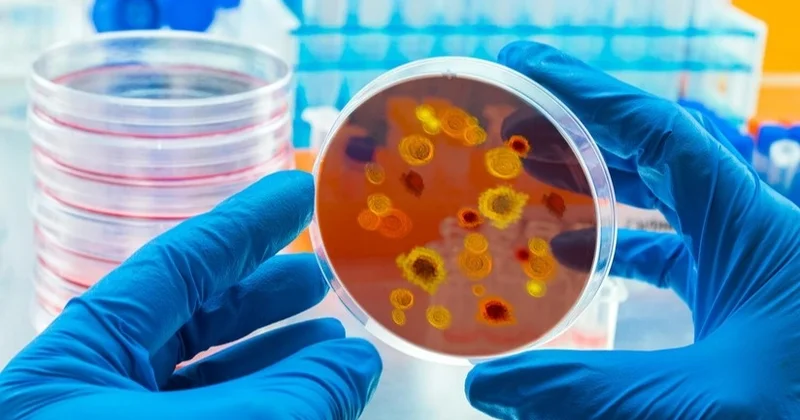
Еуропада қауіпті инфекция тарап жатыр

Еуропада қауіпті инфекция тарап жатыр
Qazaq24.com, Inform.KZ дереккөзінен алынған ақпаратқа сүйене отырып жаңалық таратады..
Манчестер университетінің жұқпалы аурулар жөніндегі сарапшысы Дэвид Деннингтің айтуынша, тері ауруының бұл түрі қызыл, қышитын бөртпелерді тудырады. Ол ең алдымен шап, жамбас және бөкседе пайда болады.
Ұлыбританияда соңғы үш жылда Trichophyton indotineae инфекциясының саны 500% өскен. Ауру әртүрлі жолдар арқылы жұғады.
Сарапшы Дэвид Деннинг тері ауруының таралуы тез жүретінін және бүкіл әлемде басты мәселеге айналатынын айтты.
Айта кетейік, Швецияда жүрек-қан тамырлары ауруларынан болатын өлім екі есе төмендеді.
 Бұл тақырыптағы басқа жаңалықтар:
Бұл тақырыптағы басқа жаңалықтар:Гонконг тұмауы немесе H3N2: бұл вирусты инфекция несімен қауіпті
18 Қараша 2025 21:51
Қазақстанда Гонконг тұмауы тарап жатыр
20 Қараша 2025 06:22
Үндістанда емделмейтін вирус тарап жатыр
25 Қаңтар 2026 10:13
Гонконг тұмауы жедел тарап жатыр ДДҰ
17 Желтоқсан 2025 09:45
Референдум алдында жалған видеоматериалдар тарап жатыр
09 Наурыз 2026 17:27
 Көрілімдер:80
Көрілімдер:80 Бұл хабарлама дереккөзден мұрағатталған 26 Қараша 2025 10:50
Бұл хабарлама дереккөзден мұрағатталған 26 Қараша 2025 10:50 



 Кіру
Кіру
 Жаңалықтар
Жаңалықтар Ауа райы
Ауа райы Магниттік дауылдар
Магниттік дауылдар Намаз уақыты
Намаз уақыты Қымбат металдар
Қымбат металдар Валюта конвертері
Валюта конвертері Кредит есептегіш
Кредит есептегіш Криптовалюта бағамы
Криптовалюта бағамы Жұлдыздар
Жұлдыздар Сұрақ - Жауап
Сұрақ - Жауап Интернет жылдамдығын тексеріңіз
Интернет жылдамдығын тексеріңіз Қазақстан радиосы
Қазақстан радиосы Қазақстан телевизиясы
Қазақстан телевизиясы Біз туралы
Біз туралы

Ең көп оқылғандар
Ең көп оқылғандар



















